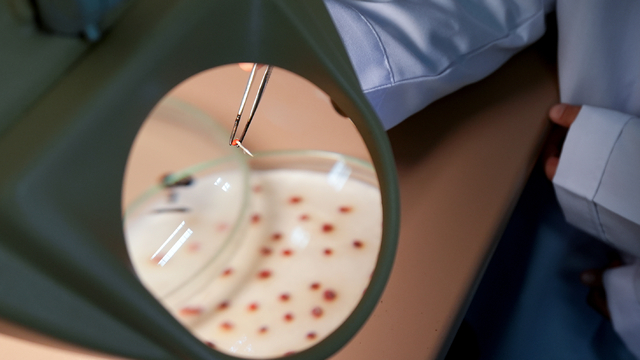
Galeri

Öğrenciler "yeşil vatan" için en hızlı filizlenen tohum topunu araştırdı
MELİKE BALKAYA - İzmir'de ortaokul öğrencileri, orman yangınlarında zarar gören alanların en kısa sürede yeşile bürünmesine katkı sağlamak amacıyla başlattıkları araştırma projesinde, doğada hızlı filizlenen tohum topunun içeriğini belirledi.

MELİKE BALKAYA - İzmir'de ortaokul öğrencileri, orman yangınlarında zarar gören alanların en kısa sürede yeşile bürünmesine katkı sağlamak amacıyla başlattıkları araştırma projesinde, doğada hızlı filizlenen tohum topunun içeriğini belirledi.
Yangınlardan zarar gören orman alanlarından etkilenen Karşıyaka Bilim ve Sanat Merkezi öğrencileri, alanların en kısa sürede tekrar eski haline dönüşmesine destek vermek için danışman öğretmenlerinin desteğiyle çalışma başlattı.
"Yeşil bir gelecek, ideal tohum topuyla başlar" sloganıyla yola çıkan öğrenciler, Ege Üniversitesi Emine Erdoğan Tohum Bilimi ve Teknolojisi Enstitüsü desteğiyle bitki oluşumunu geliştirmek, toprağı canlandırmak ve havalandırmak için toprağa atılan topların hangi malzemeyle hazırlandığında daha etkili sonuç verdiğini ortaya koymak için çalışma yürüttü.
Torf, talaş, hindistan cevizi lifi, un, kil ve kompost gibi doğal malzemelerden beş farklı türde tohum topu hazırlandı. Hazırlanan tohum topları, enstitü laboratuvarlarında aynı ısı ve nem koşullarında 4-6 hafta boyunca gözlemlendi. Düzenli aralıklarla filizlenme oranları, bitki boyları ve gelişim sürelerini ölçen öğrenciler, topladıkları verileri tablo ve grafiklerle değerlendirdi.
Çalışma sonucunda alternatifler arasında en kısa sürede filizlenen tohum topu içeriği belirlendi.
- "Hindistan cevizi lifi en başarılı sonucu verdi"
Proje danışmanı öğretmen Gerçek Güvercin, AA muhabirine öğrencilerin bu projeye başlamasında orman yangınlarının yol açtığı zararın ve doğaya karşı duydukları sorumluluk bilincinin etkili olduğunu söyledi.
Öğrencilerin, hazırlanan tohum toplarıyla hem bilimsel bir çalışma yaptıklarını hem de günlük yaşamlarında bile doğaya katkı sağlayabilecek bir çözüm yoluna ulaştıklarını ifade eden Güvercin, "Yeşil vatanımızı çok seviyoruz. Doğa bizim geleceğimiz. En kısıtlı bütçeyle ormanlarımızı tekrar nasıl yeşertebiliriz düşüncesiyle yola çıktık. Tohum toplarını insanlar pikniğe, dağ yürüyüşlerine, ormanlara gezmeye gittiklerinde sağa sola bıraktıklarında mutlaka çimlendiklerini göreceklerdir. Çok daha pratik, uygulanabilir." ifadelerini kullandı.
Projenin Ege Üniversitesi Emine Erdoğan Tohum Bilimi ve Teknolojisi Enstitüsü Koordinatörü Dr. Ebru Kavut ise ortaokul öğrencileriyle çalışarak, küçücük bir tohumun bile bir bitki örtüsü oluşturabileceğini göstermek ve bu konuda farkındalık kazandırmak istediklerini ifade etti.
Hindistan cevizi lifinin başarılı sonucu verdiğini dile getiren Kavut, "Lifler birbirine tutunduğu için doğaya bırakıldığında kolay kolay birbirini bırakmayacak ve tohumlara da kararlı bir ortam oluşturacak. Çimlenmeleri için uygun bir ortam sağlayacağını düşünüyoruz." diye konuştu.
Projede yer alan 5. sınıf öğrencilerinden Ekin Serra Okudan ise çalışmaya başlamalarındaki en büyük motivasyonun yaz aylarında yaşanan büyük orman yangınları olduğunu kaydederek, "Ağaçlarımız, doğamız yandı ve yok oldu. Biz de bu yüzden 'tohum topu' diye bir proje yapmaya karar verdik." dedi.
Öğrencilerden Alya Deniz Bulgurcu ise projeden elde edilen sonuçları çevresindeki insanlarla da paylaştığını ve bu sayede onları da bilinçlendirdiklerini söyledi.
Anadolu Ajansı, DHA ve İHA tarafından geçilen tüm İzmir haberleri, bu bölümde Haberturk.com editörlerinin hiçbir editoryal müdahalesi olmadan otomatik olarak ajans kanallarından geldiği şekliyle yer almaktadır. İzmir Haberleri alanında yer alan haberlerin hepsinin hukuki muhatabı haberi geçen ajanslardır.